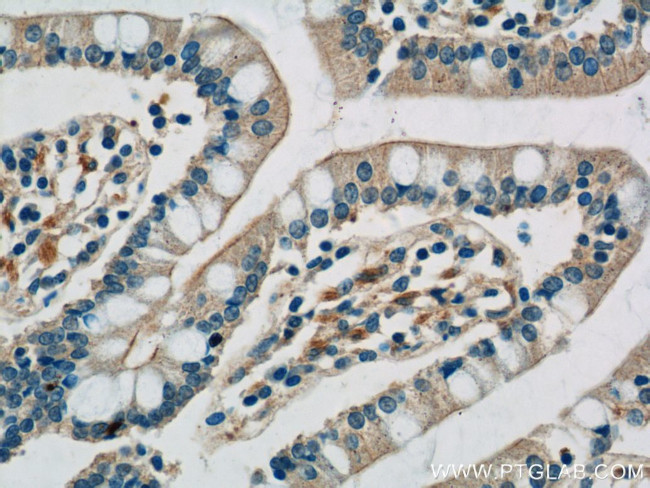
TLR7 Antibody in Immunohistochemistry (Paraffin) (IHC (P))

Search
Proteintech
TLR7 Polyclonal Antibody
{{$productOrderCtrl.translations['antibody.pdp.commerceCard.promotion.promotions']}}
{{$productOrderCtrl.translations['antibody.pdp.commerceCard.promotion.viewpromo']}}
{{$productOrderCtrl.translations['antibody.pdp.commerceCard.promotion.promocode']}}: {{promo.promoCode}} {{promo.promoTitle}} {{promo.promoDescription}}. {{$productOrderCtrl.translations['antibody.pdp.commerceCard.promotion.learnmore']}}
产品信息
17232-1-AP
种属反应
已发表种属
宿主/亚型
分类
类型
抗原
偶联物
形式
浓度
规格
纯化类型
保存液
内含物
保存条件
运输条件
产品详细信息
Immunogen sequence: LLGARWFPK TLPCDVTLDV PKNHVIVDCT DKHLTEIPGG IPTNTTNLTL TINHIPDISP ASFHRLDHLV EIDFRCNCVP IPLGSKNNMC IKRLQIKPRS FSGLTYLKSL YLDGNQLLEI PQGLPPSLQL LSLEANNIFS IRKENLTELA NIEILYLGQN CYYRNPCYVS YSIEKDAFLN LTKLKVLSLK DNNVTAVPTV LPSTLTELYL YNNMIAKIQE DDFNNLNQLQ ILDLSGNCPR CYNAPFPCAP CKNNSPLQIP VNAFDALTEL KVLRLHSNSL QHVPPRWFKN INKLQELDLS QNFLAKEIGD AKFLHFLPSL IQLDLS (24-348 aa encoded by BC033651)
靶标信息
TLR7 is a 10 amino acid long highly conserved membrane protein belonging to the Toll-like receptor (TLR) family with 27 LRR (leucine-rich) repeats and a TIR domain. TLR7 plays a fundamental role in pathogen recognition and activation of innate immunity. TLR7 is activated by infections with single-stranded RNA viruses, including influenza virus and vesicular stomatitis virus (VSV). TLR7 is predominantly expressed in lung, placenta, and spleen, and lies in close proximity to another family member, TLR8. TLR7 also acts via MyD88 and TRAF6, leading to NF-kappaB activation, cytokine secretion and the inflammatory response. TLR7 recognize pathogen-associated molecular patterns (PAMPs) that are expressed on infectious agents, and mediate the production of cytokines necessary for the development of effective immunity.
仅用于科研。不用于诊断过程。未经明确授权不得转售。
生物信息学
蛋白别名: RP23-139P21.3; Toll-like receptor 7; toll-like receptor 7-like; unnamed protein product
基因别名: IMD74; RGD1563357; SLEB17; TLR7; TLR7-like; UNQ248/PRO285
UniProt ID: (Human) Q9NYK1, (Mouse) P58681
Entrez Gene ID: (Human) 51284, (Mouse) 170743, (Rat) 317468